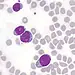
Nova terapia se mostra promissora contra câncer raro 8 Células linfoblásticas T da leucemia aguda na medula óssea: poucas opções quando o tratamento principal falha - (crédito: WikimediaCommons/Divulgação )

Uma candidata aprovada no cadastro de reserva do concurso para Professor de Pré-Escola de Rio Branco conseguiu, na Justiça, o direito de ser imediatamente nomeada e empossada. A determinação, divulgada na edição desta sexta-feira,12, do Diário da Justiça, foi dada pela Primeira Câmara Cível do Tribunal de Justiça do Acre, que considerou ilegal a preterição ocorrida após o Município abrir um processo seletivo temporário mesmo com o concurso ainda vigente.
A decisão reformou o entendimento de primeira instância, que havia negado liminar para a convocação. Segundo o processo, candidatos melhor classificados desistiram da vaga, fazendo com que a candidata passasse a figurar dentro do número de vagas efetivamente surgidas. Mesmo assim, a Administração optou por contratar temporários para a mesma função, o que foi considerado comportamento contraditório.
Os desembargadores aplicaram entendimento do Supremo Tribunal Federal segundo o qual a expectativa de direito do candidato aprovado fora das vagas se transforma em direito subjetivo à nomeação quando há preterição arbitrária e comprovada necessidade de pessoal. Para o colegiado, esse foi justamente o cenário no concurso de Professor de Pré-Escola.
A Justiça também rejeitou a tese de que a liminar seria irreversível, afirmando que a nomeação pode ser revertida posteriormente caso o mérito do mandado de segurança seja negado. Considerou ainda que a demora prejudicaria a candidata, sobretudo pelo impacto salarial e no tempo de serviço para fins de carreira.
Com isso, o município de Rio Branco deve nomear e dar posse à candidata de forma imediata.